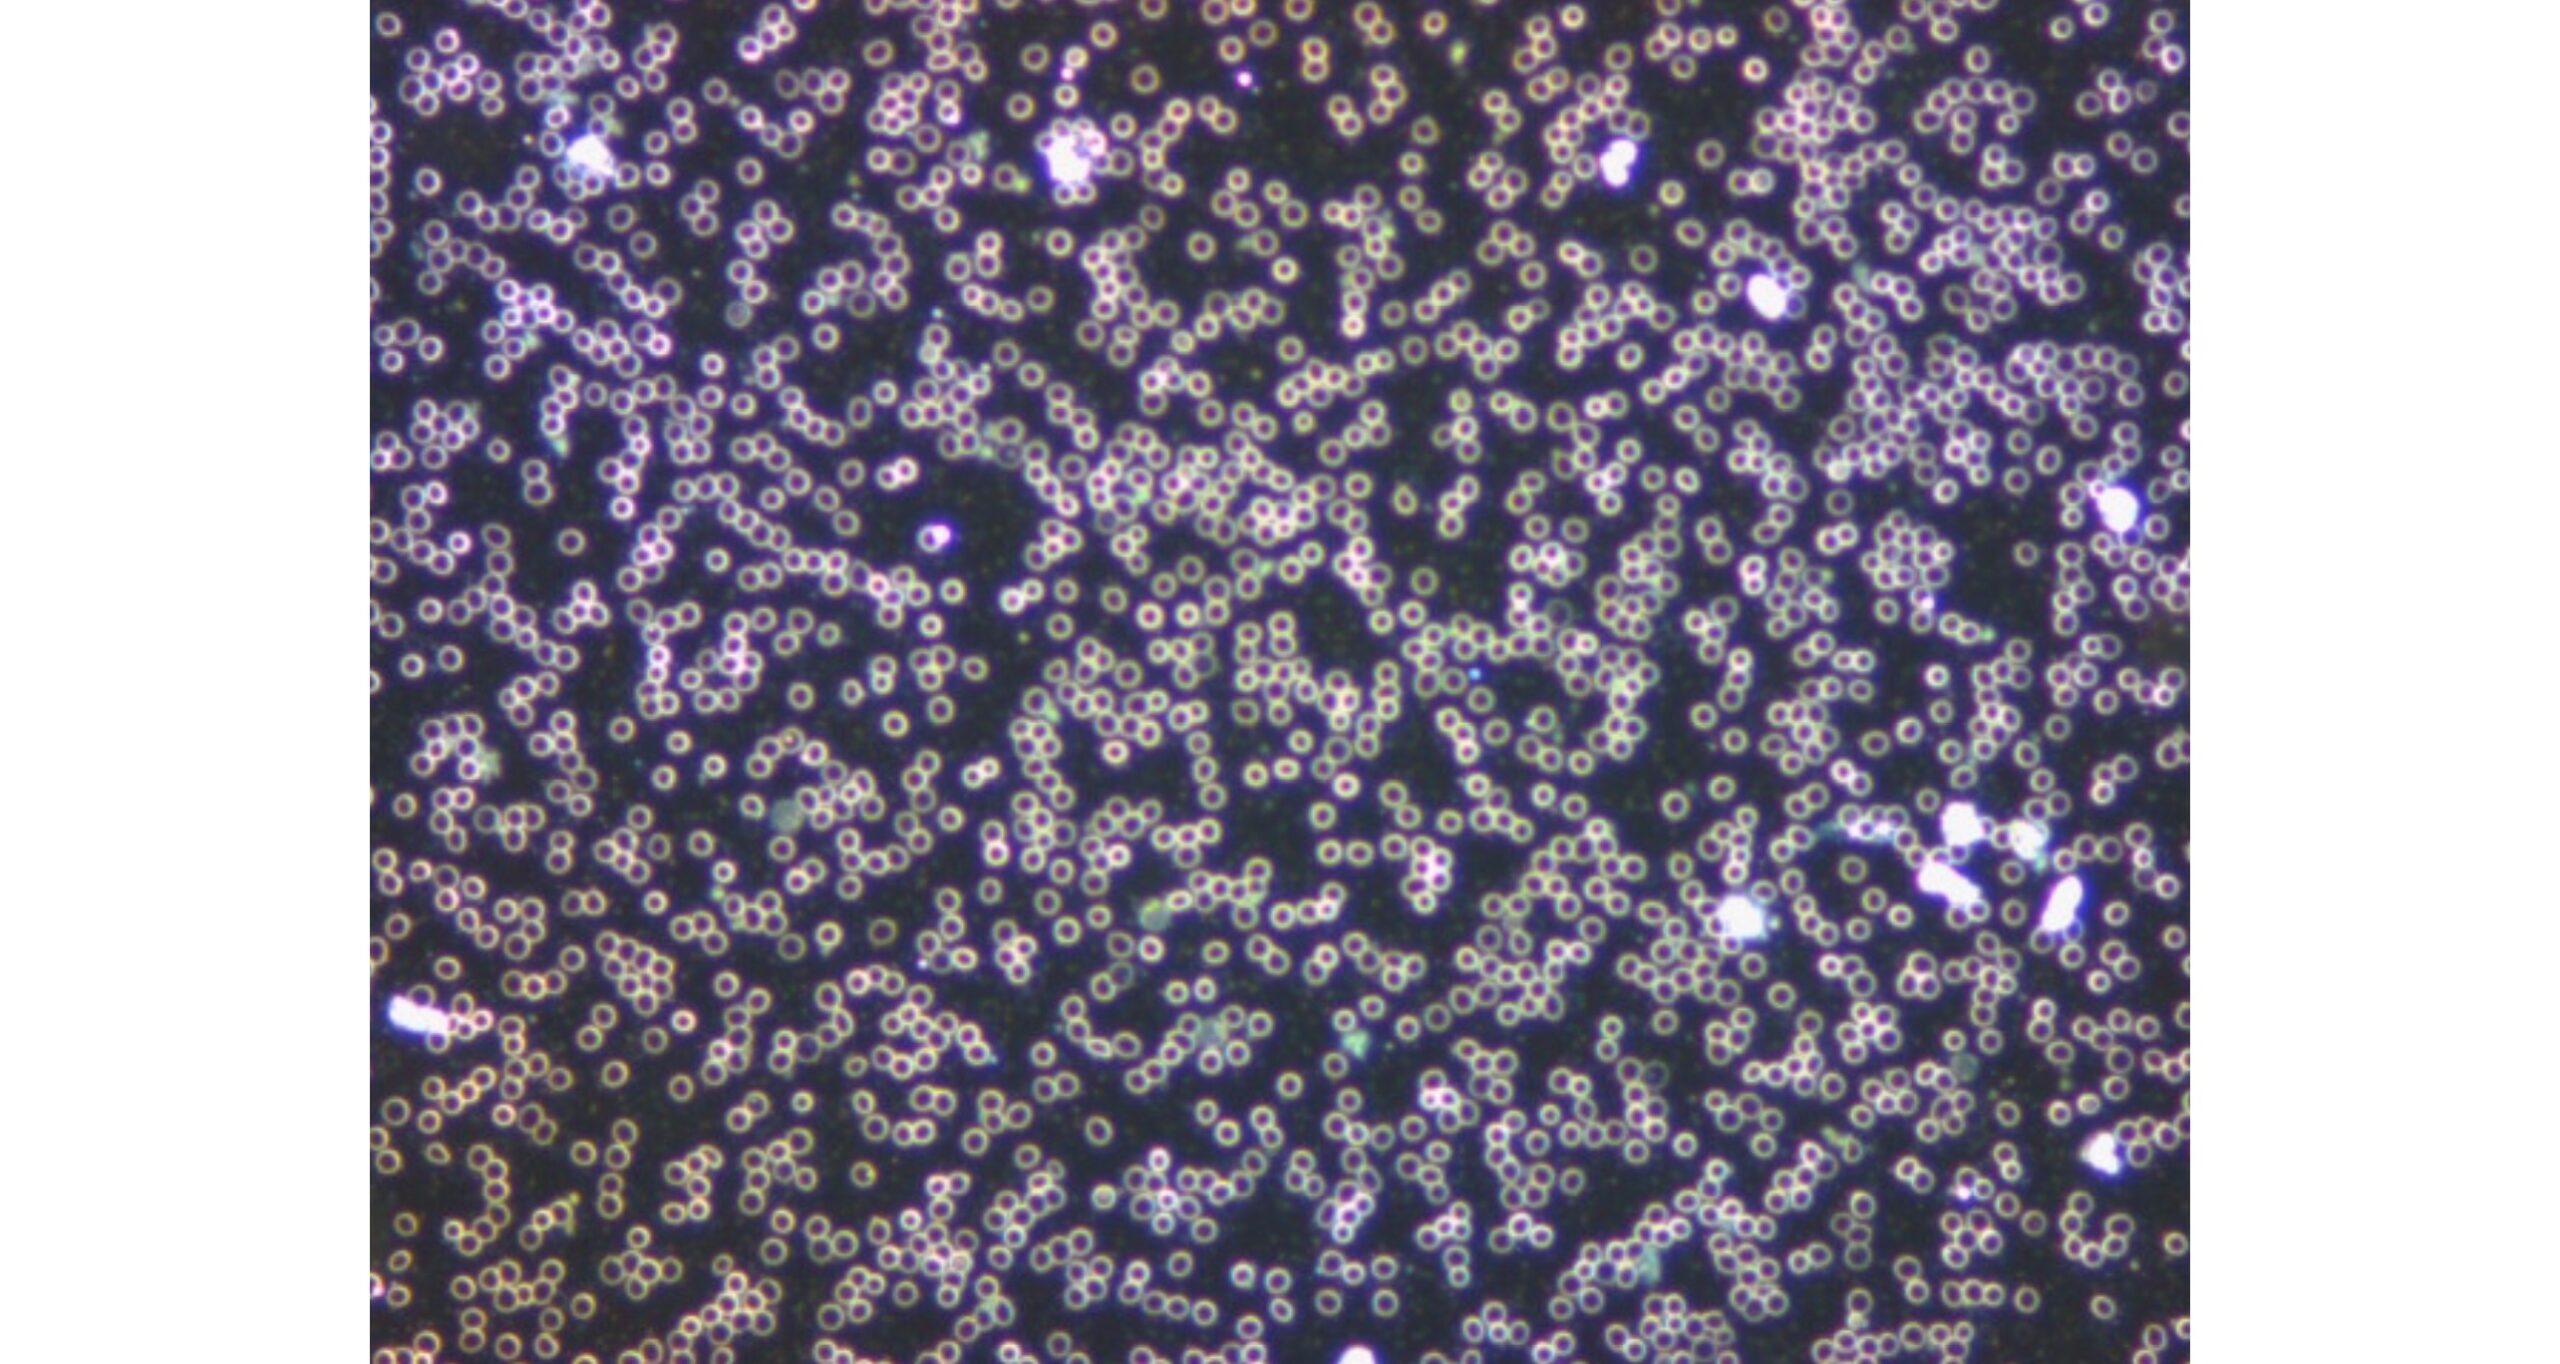

Research of R.A.I.L. Water
In 1984, I was healed by the water from Lourdes. I was paralyzed, confined to a wheelchair, and today I am conducting research on the structure of this water. Is it just a coincidence? I still wonder about that myself.
Thirty years later, in 2013, I met Dr. Masaru Emoto, a renowned specialist in the study of water structure. His research showed that water responds to the world around us, recognizes words and thoughts, distinguishes good from evil, perceives our faith, and even anticipates future events. Is this truly the case? That was the first time I saw the structure of Lourdes water…
I would like to take a few steps further down this path, even though I am not a scientist. The series of studies we are conducting allows us to look deeper into the world of water and understand what water wants to tell us.
I invite you on this journey into the unknown…




Description of the Device and Research Methodology
For the measurements, a system was used consisting of a Pyris 1 DSC power-compensated differential scanning calorimeter (DSC) and an Intracooler 2P cooling device by Perkin-Elmer (USA).
Detailed, systematic research carried out at one of Poland’s respected and experienced research institutions revealed and unequivocally confirmed the irreversible impact of the LWT Base on selected fundamental and highly significant physical properties of water from the perspective of life on Earth—its thermal properties.
The most remarkable and unexpected effect of the LWT Base on water is the increase of Gibbs free energy (thermodynamic potential) in liquid water.
Change in the Specific Heat of Water Exposed to the Active Base
1. The melting temperature of “LWT” ice was measured at 1.7 °C (274.85 K), while the literature value for ice melting is 0 °C (273.15 K).
2. The heat of fusion of “LWT” ice was determined as 325.84 J/g (2.4% lower compared to the literature value of 333.85 J/g).
3. The specific heat of “LWT” liquid water was 3.98 J/gK, on average 2.6% lower compared to the Cp of the reference water (4.09 J/gK). Similarly, the specific heat of “LWT” ice was on average 3.2% lower compared to the Cp of ice from reference water—for example, 1.92 J/gK vs. 1.98 J/gK at 273.15 K.




The Effect of Structured Water
on Human Blood Erythrocytes
The blood of the examined person was initially analyzed using a dark-field microscope without the influence of the ALIA water revitalization device. In addition to the dark color of the blood, the test also showed slowed blood flow, indicating a lack of oxygen in the tissue and blood overacidity. This is very clearly visible in the “concentration of erythrocytes.” Red blood cells clump together and therefore remain immobile. The clusters of red blood cells are caused by an excess of free radicals or blood overacidity. It may also result from electrosmog. This disturbs the viscosity of the red blood cell walls, causing them to stick together. The presence of such formations indicates that the body is not coping well.
Change
The blood was once again collected and analyzed. In fact, when the blood was drawn, a clear change in its color to bright red could be observed, which immediately indicates an increase in oxygen content. Previously, such blood oxygenation was only possible through much more complex ozone therapy.
The positive effect of the ALIA water harmonization device on the blood of a living organism presented here offers a vast potential for the regeneration of people and the environment, including the harmonization of food and plants. The effects of electrosmog may also be compensated. In the future, precise research on plant growth, disease recovery, and the regeneration of all waters on this Earth will provide a comprehensive overview of the interconnections that are also established in the microcosm and macrocosm through water restructuring in the sense of natural order.